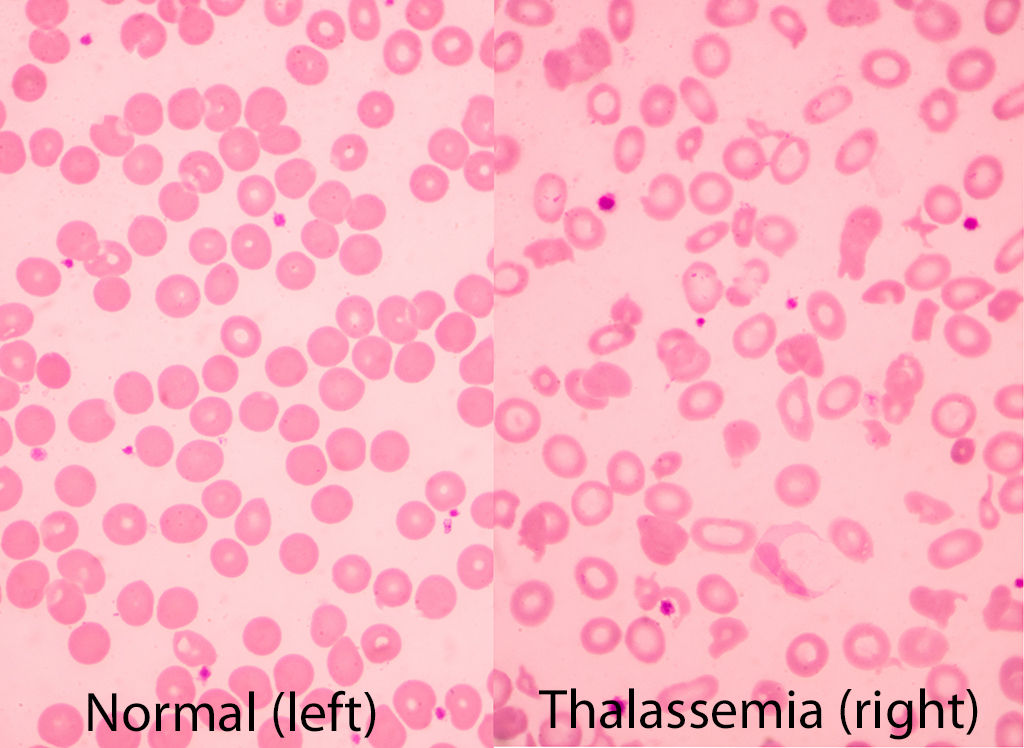
The Chemistry of Cooley's Anemia

Abstract
Young parents, Max and Andrea Forest, learn that their child is suffering from the genetic disorder, thalassemia. Treatment requires a lifetime commitment to whole blood transfusion and chelation therapy, both of which must be administered on a daily to weekly basis. Students read the case, answer a series of questions, and then decide how they would treat the child if they were the parents. The case was developed to introduce students to the role of metal ions and coordination chemistry in biological systems. It would be appropriate for use in courses in biochemistry, molecular biology, bioinorganic chemistry, and bioethics, among others.